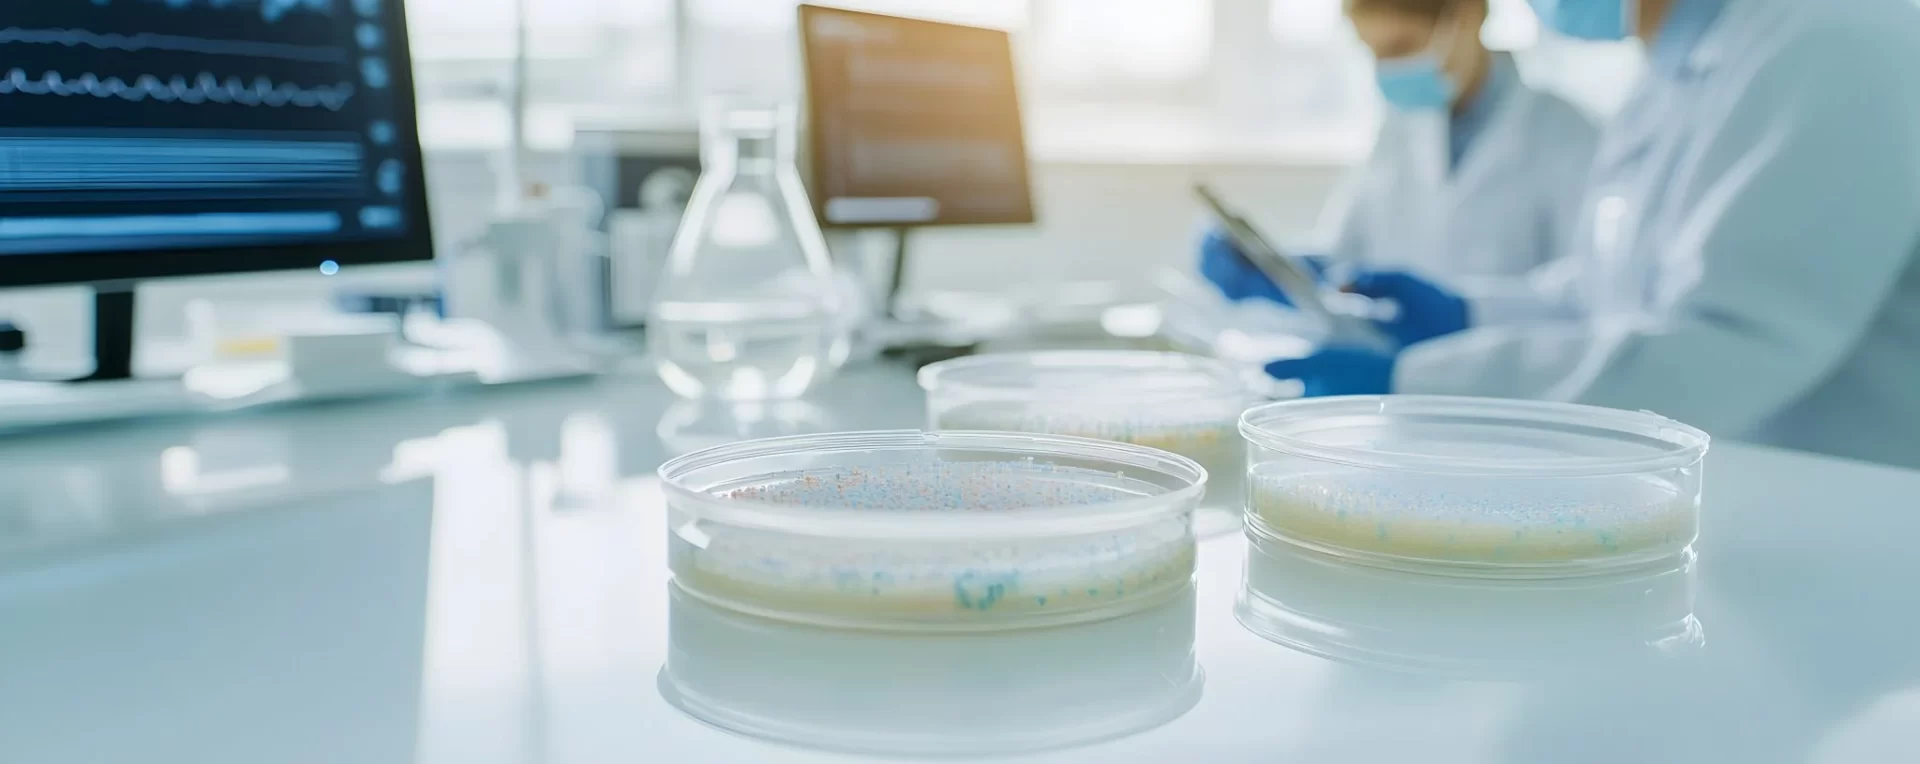
The Future of Eye Care: How 3D Bioprinting Could Transform Corneal Transplants

Corneal Bioprinting: A Promising Future for Vision Restoration

What Is Corneal Bioprinting?
Corneal blindness affects millions worldwide. Although corneal transplants are highly effective, they rely on donated tissue, which isn’t always available. Thankfully, new technology could offer a powerful alternative: 3D bioprinting of the cornea.
Bioprinting uses 3D printers and “bioinks”—materials made of living cells and support substances—to create tissues. Unlike traditional methods, bioprinting allows for greater precision, quicker production, and layered construction that mimics natural tissue.
The cornea—a transparent, dome-shaped layer protecting the eye—is especially suited for this innovation. Since it lacks blood vessels, scientists can avoid the complex task of printing microvascular networks. This feature makes the cornea a strong candidate for early success in bioprinting.
Benefits of Corneal Bioprinting
One of the key benefits is customization. With digital models, printers can adjust the size, shape, and curvature of each cornea to match the patient’s eye precisely.
Bioprinting can also speed up production and ensure consistent quality. This could help reduce the global shortage of donor corneas. Additionally, researchers may use printed corneas to study diseases or test treatments—without relying on human donors.
Challenges Ahead
Despite its promise, several challenges remain before doctors can use bioprinted corneas in patients.
First, replicating the cornea’s unique shape and clarity is difficult. Bioinks must remain clear and flexible yet strong enough for surgical use—an ongoing challenge.
Second, real corneal tissue includes several layers of cells: epithelial cells, keratocytes, and endothelial cells. Scientists are still working on printing functional corneas with all these cell types. They also continue to study how printing affects cell behavior, including growth and function.
Stem cells might help. They can turn into different types of corneal cells. However, they also raise concerns, including high cost, ethical issues, and limited supply.
Looking Ahead
Emerging tools like 4D bioprinting—which lets tissue change over time—and cell electrowriting—which enables ultra-precise layering of collagen—are bringing us closer to fully functional, bioprinted corneas.
As with any medical breakthrough, safety and ethics are essential. Bioprinted corneas must pass rigorous testing and meet strict standards. Access, affordability, and long-term results also require attention.
In Summary
Corneal bioprinting offers real hope for restoring vision. While it’s not ready for clinical use yet, research continues to advance. At our clinic, we remain dedicated to innovation and to delivering the highest level of care for our patients.
—
Source https://pubmed.ncbi.nlm.nih.gov/29772228/